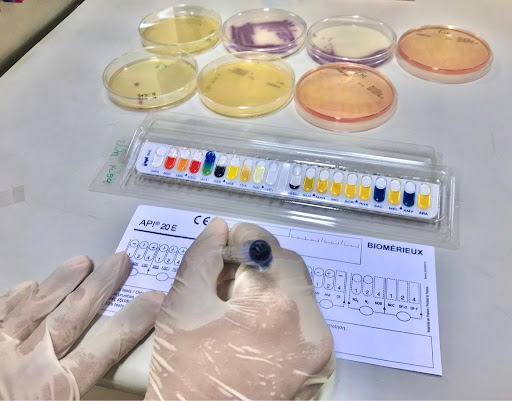

อาหารเลี้ยงจุลินทรีย์ออร์แกนิก: ทางลัดสู่โยเกิร์ต–น้ำส้มสายชู Organic มาตรฐาน
ปัจจุบันความต้องการผลิตภัณฑ์อาหารออร์แกนิกเติบโตอย่างรวดเร็ว อุตสาหกรรมอาหารหมักได้เผชิญกับอุปสรรคสำคัญที่ขัดขวางการพัฒนาผลิตภัณฑ์ให้ตอบสนองความต้องการของตลาดพรีเมียม ปัญหาหลักที่ผู้ประกอบการต้องเผชิญคือการขาดแคลนสื่อเลี้ยงจุลินทรีย์ที่ได้รับการรับรองออร์แกนิก ซึ่งเป็นองค์ประกอบสำคัญในการเพาะเลี้ยงและเก็บรักษาสายพันธุ์จุลินทรีย์สำหรับผลิตอาหารหมักประเภทต่างๆ เช่น โยเกิร์ตและน้ำส้มสายชู
มหาวิทยาลัยขอนแก่นจึงได้ริเริ่มโครงการวิจัยและพัฒนาที่สาขาเทคโนโลยีชีวภาพ คณะเทคโนโลยี ร่วมกับห้องปฏิบัติการกลาง ตั้งแต่วันที่ 1 มีนาคม ถึง 30 สิงหาคม 2568 เป็นระยะเวลา 6 เดือน เพื่อพัฒนาสื่อเลี้ยงจุลินทรีย์ออร์แกนิกที่จะเป็นกุญแจสำคัญในการปลดล็อกศักยภาพของอุตสาหกรรมอาหารหมักออร์แกนิกของไทย
โครงการนี้สะท้อนถึงการตอบสนองต่อเป้าหมายการพัฒนาที่ยั่งยืนในหลายมิติ ในด้านการศึกษาที่มีคุณภาพ โครงการได้จัดกิจกรรมและการอบรมเพื่อส่งเสริมการเรียนรู้ตลอดชีวิตด้านเทคโนโลยีชีวภาพและการผลิตอาหารออร์แกนิก สำหรับการพัฒนาอุตสาหกรรมและนวัตกรรม โครงการได้มุ่งเน้นการพัฒนานวัตกรรมเชิงพาณิชย์ที่สามารถสร้างรายได้จากภาคอุตสาหกรรม พร้อมทั้งพัฒนานวัตกรรมเพื่อแก้ไขปัญหาสังคม ส่วนการผลิตและการบริโภคที่ยั่งยืน โครงการได้ส่งเสริมการให้บริการวิชาการและจัดอบรมด้านความยั่งยืนแก่สาธารณะ กระบวนการดำเนินงานได้รับการออกแบบอย่างเป็นระบบ เริ่มต้นด้วยการจัดหาวัตถุดิบจากถั่วเหลืองที่ได้รับการรับรองออร์แกนิก ต่อด้วยการออกแบบสูตรสื่อเลี้ยงที่เหมาะสม จากนั้นจึงทดสอบประสิทธิภาพโดยเปรียบเทียบกับ MRS ที่ใช้ในการค้า ดำเนินการแช่เยือกแข็งแบบ freeze-dry เพื่อรักษาชีวิตของจุลินทรีย์ ติดตามอายุการเก็บรักษา ออกแบบฉลากและบรรจุภัณฑ์ และสรุปผลเพื่อยื่นขออนุสิทธิบัตร
วัตถุประสงค์หลักของโครงการคือการพัฒนาสูตรสื่อเลี้ยงออร์แกนิกจากถั่วเหลือง การประเมินการเจริญเติบโต การผลิตกรด และความอยู่รอดของ Lactic Acid Bacteria (LAB) และ Acetobacter รวมถึงการติดตามอายุการเก็บรักษาและการวิเคราะห์ต้นทุนการผลิต
ตัวชี้วัดหลักที่กำหนดไว้แสดงให้เห็นถึงความสำเร็จของโครงการอย่างชัดเจน โครงการได้สร้างต้นแบบสื่อเลี้ยงออร์แกนิกที่ใช้งานได้จริงในระดับ TRL4 เมื่อจบการดำเนินงาน อัตราการรอดชีวิตของ Lactiplantibacillus plantarum หลังการ freeze-dry มีค่าเฉลี่ย 73.5% ซึ่งยืนยันศักยภาพของสูตรที่พัฒนาขึ้น พร้อมทั้งสำเร็จในการทดลองกับ Acetobacter sp. และการวิเคราะห์ต้นทุนการผลิตตามไทม์ไลน์ที่กำหนด

ผลลัพธ์ที่ได้รับจากโครงการมีความครบถ้วนและเป็นรูปธรรม ได้แก่ สูตรสื่อเลี้ยงออร์แกนิกที่สมบูรณ์ ผลการทดสอบการเจริญเติบโตและการผลิตกรดเมื่อเปรียบเทียบกับ MRS ที่ใช้ในการค้า รายงานการศึกษาอายุการเก็บรักษา เอกสารวิเคราะห์ต้นทุน และแผนการขออนุสิทธิบัตรพร้อมการออกแบบฉลากและบรรจุภัณฑ์
ผลกระทบเชิงเทคนิคที่เกิดขึ้นแสดงให้เห็นถึงความสำเร็จของนวัตกรรม สื่อเลี้ยงออร์แกนิกที่พัฒนาขึ้นสามารถสนับสนุนการเจริญเติบโตของ L. plantarum และรักษาชีวิตของจุลินทรีย์หลังการแห้งได้ดีถึง 73.5% แม้ว่าการเติบโตและการสร้างกรดของ MRS จะสูงกว่า แต่สื่อเลี้ยงออร์แกนิกมีความจำเป็นอย่างยิ่งเมื่อต้องการผลิตภัณฑ์ที่ปลอดสารสังเคราะห์ตามเกณฑ์ ออร์แกนิกในมิติเชิงเศรษฐกิจและสังคม โครงการได้เปิดทางให้ผู้ประกอบการขนาดกลางและขนาดย่อม (SMEs) รวมถึงผู้ประกอบการท้องถิ่น สามารถอัปเกรดสินค้าเดิมให้เป็นผลิตภัณฑ์ออร์แกนิก ซึ่งจะช่วยเพิ่มมูลค่าและสร้างความเชื่อมั่นในตลาดสุขภาพที่มีการเติบโตอย่างรวดเร็ว การพัฒนาสื่อเลี้ยงจุลินทรีย์ออร์แกนิกนี้ไม่เพียงแต่แก้ไขปัญหาการขาดแคลนชิ้นส่วนสำคัญในห่วงโซ่การผลิตอาหารหมักออร์แกนิก แต่ยังเป็นการสร้างโอกาสใหม่ให้กับผู้ประกอบการในการเข้าถึงตลาดพรีเมียมออร์แกนิก การมีสื่อเลี้ยงที่ได้รับการรับรองออร์แกนิกจะช่วยให้ผู้ผลิตสามารถขอการรับรองมาตรฐานออร์แกนิกสำหรับผลิตภัณฑ์ของตนได้ นอกจากนี้ โครงการยังได้สร้างองค์ความรู้และเทคโนโลยีที่สามารถถ่ายทอดสู่ชุมชนและอุตสาหกรรม ผ่านการจัดกิจกรรมอบรมและการให้บริการวิชาการ ซึ่งจะช่วยยกระดับความรู้และทักษะของบุคลากรในอุตสาหกรรมอาหารหมัก
โครงการ “อาหารเลี้ยงจุลินทรีย์ออร์แกนิก” จึงเป็นตัวอย่างที่ชัดเจนของการวิจัยและพัฒนาที่มุ่งเน้นการแก้ไขปัญหาเฉพาะของอุตสาหกรรม โดยการสร้างนวัตกรรมที่ตอบสนองความต้องการของตลาดและสนับสนุนการพัฒนาอย่างยั่งยืน นวัตกรรมนี้ไม่เพียงแต่เป็นทางลัดสู่การผลิตโยเกิร์ตและน้ำส้มสายชูออร์แกนิกมาตรฐาน แต่ยังเป็นเครื่องมือสำคัญในการขับเคลื่อนอุตสาหกรรมอาหารไทยสู่ความยั่งยืนและความเป็นเลิศในตลาดโลก
ลิงก์ข่าว, เพจ Facebook หรือสื่ออื่นๆ ที่เกี่ยวข้อง https://te.kku.ac.th/board/?page_id=1948
ผู้ให้ข้อมูลติดต่อกลับ นางสาวพรชวรัตน์ ฐานมั่น / Line id : kaew.p